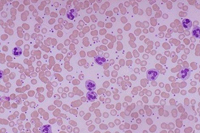
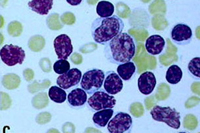

- 生活
- 常識 用藥指南 營養(yǎng)常識 護(hù)理 急救 戶外知識 居家常識 生活竅門 選購技巧 健康日 美容 女人 兩性情感心理 情感心理 倫理道德 婚姻堡壘 男性 私房話 家居
- 養(yǎng)生
- 飲食 食療養(yǎng)生 飲食安全 健康廚房 烹飪技巧 減肥 飲食減肥 運(yùn)動(dòng)減肥 中醫(yī)減肥 局部減肥 健身 瑜伽 家庭健身 運(yùn)動(dòng)健身 辦公室健身 中醫(yī) 中藥 穴位 按摩藥膳 藥膳 老人養(yǎng)生
- 母嬰
- 備孕 懷孕 新生兒 嬰兒 幼兒 優(yōu)生優(yōu)育 學(xué)齡前 孕期
- 疾病
- 內(nèi)科 外科 婦產(chǎn)科 男科 腫瘤科 兒科 五官科 急診科 傳染科 皮膚性病科 精神心理科 檢驗(yàn)檢查
- 中醫(yī)
- 養(yǎng)生保健 特色療法 湯藥方劑 疾病 中醫(yī)講座
- 原創(chuàng)欄目
- 健康播報(bào) 健康第一線 千金妙方 腧穴之道 健康我主張 病案 健康雜談 豆丁看牙記 寶寶御膳房 太極拳

- 健康一線
熊掌號

- 微信公眾號

- 手機(jī)網(wǎng)頁版

陜公網(wǎng)安備 61019002000060號
陜公網(wǎng)安備 61019002000060號